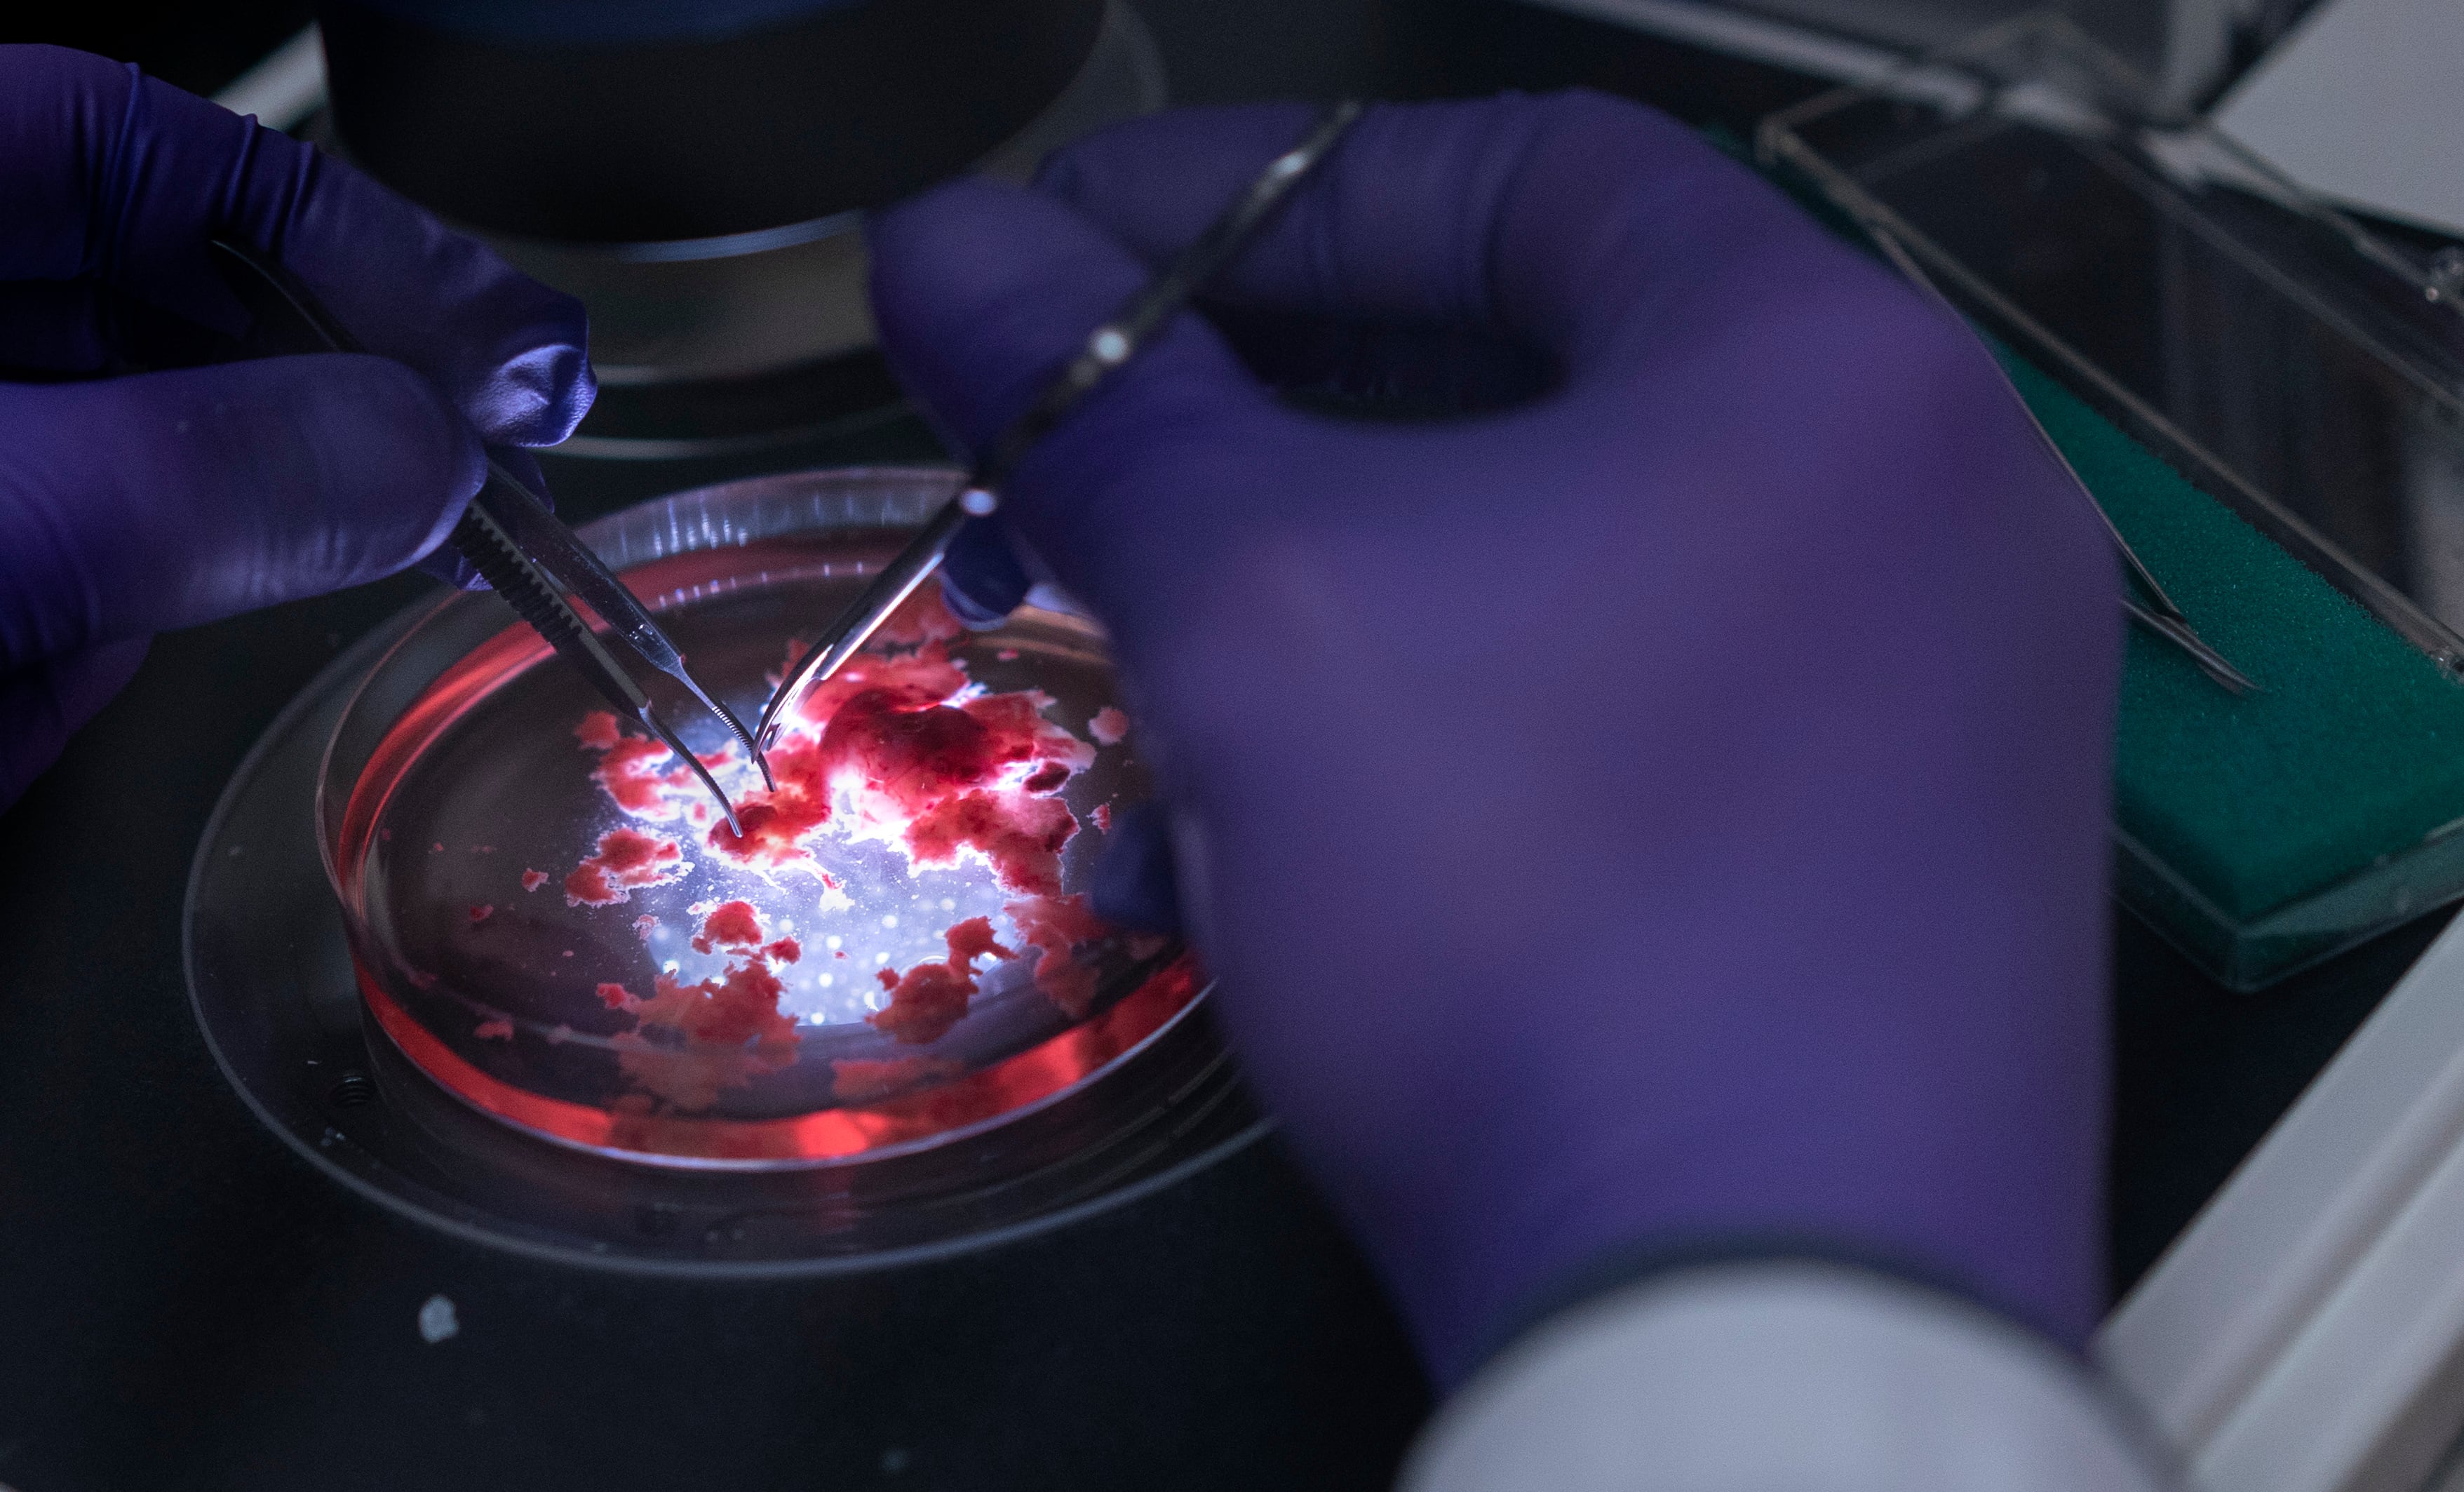
Virtudes de un pequeño cerebro

Virtudes de un pequeño cerebro
🔥 Ver noticia completa en ElPais.com 🔥
Una línea de investigación contra el síndrome de Timothy puede llevarnos a avances contra el autismo o la esquizofrenia
🔥 Ver noticia completa en ElPais.com 🔥